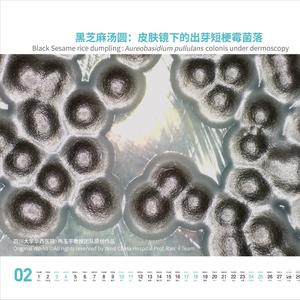

四川在线记者 魏冯
真菌还能做台历?这几天,四川大学华西医院皮肤性病科冉玉平教授团队以真菌为主题,自制的龙年台历出炉,引发网友关注。
据悉,冉玉平团队从2013年开始自制真菌台历,每月的日历配图都是原创的真菌图。和往年相比,今年这本龙年台历设计更精美,菌种也不太一样,比如出芽短梗霉菌落等还是首次面世并被展示。
为何制作真菌台历?2月2日下午,四川大学华西医院皮肤性病科教授、中国菌物学会副理事长冉玉平解答记者问题。
医学也“浪漫”
在实验室寻找“五月繁花”,捕捉“黑芝麻汤圆”
2月2日,冉玉平教授介绍“真菌台历”时,对内附配图如数家珍。
2024年2月配图是“黑芝麻汤圆”。“这是皮肤镜下的出芽短梗霉菌落,我们发现这是一种罕见的可能接触某些植物后感染的真菌。”冉玉平教授介绍。

2月显示从皮损中分离的出芽短梗霉菌落,在皮肤镜下拍摄的。看起来菌落表面有致密的生物膜覆盖,有白色边缘,很像黑芝麻汤圆。受访者供图
2024年5月配图是“五月繁花”。“现在电视剧《繁花》很火,这个实际上是分离自皮肤标本的盔形毕赤酵母菌,接种在玫瑰红钠培养基上长出的菌落,在皮肤镜下放大拍摄的。”

5月繁花盛开,此图是盔形毕赤酵母菌在玫瑰红钠培养基生长的菌落,在皮肤镜下拍摄非常漂亮。受访者供图
整本日历封面是一张龙图。“这是耗时最久制作的一张原创图,由6种念珠菌在培养基上,在温度为30℃孵箱内培养72小时长出来的。”

冉玉平教授正在给记者介绍日历封面。受访者供图
龙图创作并非易事。“团队会在培养基下面放上预先打好的‘草图’。我们要培养6种菌,知道每一种菌在培养基上显示的颜色。根据龙的图像,把带菌的混悬液通过精细的接种钩描绘上去,然后再放入培养箱,让接种的菌生长。如果操作不当,整个图像也会被破坏。团队会画几个草图备选,每个平板长出的龙制作周期至少一两周,最后选出一个多彩、天然颜色的‘真菌龙’作为年历封面,使科学和艺术的有机结合能够完美体现。”冉玉平教授说。
初心
日历可以是“备忘录”“艺术品”,还能让人们了解真菌
自制真菌台历,冉玉平教授团队的灵感来自日常工作。
“我们每年会总结过去一年有哪些跟真菌相关的美丽图像给大家分享和展示,团队也会梳理新一年的全国性以及国际性的学术会议、计划进行标记,我们想把日历作为载体,做成备忘录和艺术品的融合。”冉玉平教授说,从2013年全国皮肤性病学术年会期间,他就开始做这件事。
团队坚持12年创作“真菌台历”,是想把科学和艺术结合,有助于普及真菌相关的知识,激发更多人探索医学科学的兴趣。“每一种真菌的名字对很多人来说很陌生,但它们是我们日常能够接触到的,希望让更多人了解医学不仅治病救人,也有趣味性、艺术性的一面。”冉玉平教授介绍。
实际工作中,团队会通过研究病原体、做药敏实验,把合适药物用到患者身上,将患者从痛苦当中解救出来。通过不断探索搞清楚病原菌、研究真菌特点,了解真菌是否是对某种药物耐药,在反复研究后调整治疗方案。
每张精美的真菌图背后,是团队对图片进行一系列艺术处理、搭配等的努力。“每到年末,都有国内外同行问我,什么时候出台历,这也成了团队继续自制真菌台历的动力。”冉玉平教授说。